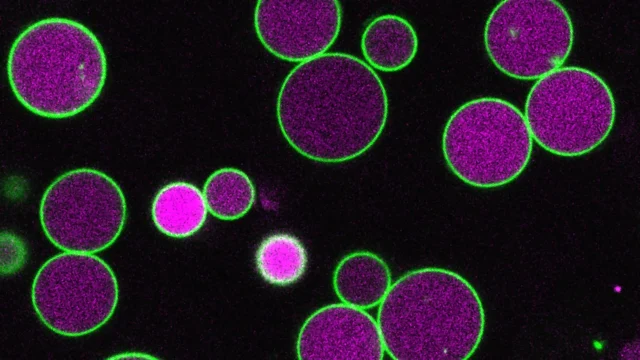

As plantas passam a maior parte de suas vidas produzindo energia por meio da fotossíntese. No entanto, durante os primeiros estágios após o início do crescimento das sementes, elas ainda não são capazes de captar luz. Durante esta breve mas crítica janela, eles dependem dos ácidos graxos armazenados. Para decompor esses ácidos graxos, as células vegetais utilizam estruturas especializadas chamadas peroxissomos, que também são encontradas nas células humanas. Devido ao seu tamanho e visibilidade, as células vegetais podem servir como um sistema útil para estudar o funcionamento dos peroxissomos.
“A planta que usamos, Arabidopsis thaliana, tem células e peroxissomos muito grandes, e podemos ver o interior deles com um microscópio óptico”, disse Bonnie Bartell, professor de Ciências Biológicas Ralph e Dorothy Looney. “Durante a fase da semente à muda, quando a planta depende de ácidos graxos para obter energia, os peroxissomos tornam-se maiores e, uma vez que a planta pode fotossintetizar, os peroxissomos voltam ao tamanho normal.”
A proteína PEX11 ajuda a controlar o tamanho do peroxissomo
A equipe de Bartel se concentrou nesses peroxissomos aumentados, especificamente em uma proteína chamada PEX11. Os cientistas sabem há muito tempo que o PEX11 desempenha um papel na ajuda à divisão dos peroxissomos. Numa nova investigação publicada na Nature Communications, a equipa descobriu que esta proteína também ajuda a controlar a expansão e contracção dos peroxissomas durante o desenvolvimento inicial das plantas.
“Os peroxissomas têm sido implicados em várias doenças humanas e são utilizados na bioengenharia”, disse Nathan Tharp, estudante de pós-graduação da Rice e principal autor do artigo. “No entanto, estudá-los pode ser bastante complicado.”
Usando CRISPR para estudar proteínas complexas
Uma estratégia comum para compreender as proteínas é desativar os genes responsáveis por produzi-las e observar os efeitos. Neste caso, a situação é mais complicada. PEX11 é produzido por cinco genes diferentes. Destruir apenas um deles terá pouco efeito, mas remover todos os cinco fará com que a planta morra. Isto torna difícil determinar a função da proteína.
Para resolver este problema, Tharp usou tecnologia avançada CRISPR para desabilitar seletivamente diferentes combinações desses cinco genes.
“Consegui usar avanços recentes no CRISPR para estudar e decompor combinações específicas desses cinco genes”, disse Tharp, que defendeu recentemente sua tese. “Foi só então que descobrimos que o PEX11 está claramente envolvido no controle do crescimento do peroxissomo desde a semente até o estágio de muda.”
Peroxissomos gigantes revelam mecanismos de controle de crescimento
Tharp projetou dois tipos de plantas mutantes, cada uma sem um conjunto específico de genes PEX11. Em ambos os casos, os peroxissomas expandiram-se conforme esperado, desde a semente até à fase de plântula. No entanto, algumas espécies não diminuem para o tamanho normal, mas continuam a crescer muito além dos limites normais. Em casos extremos, os peroxissomos se estendem de uma extremidade à outra da célula.
Essas células mutantes também não possuíam vesículas, pequenos compartimentos ligados à membrana que normalmente se formam dentro dos peroxissomos durante o processamento de ácidos graxos. Em condições normais, estas vesículas desenvolvem-se à medida que os peroxissomas crescem e parecem remover porções das suas membranas externas.
“A absorção de detritos de membrana pelas vesículas à medida que se formam pode ajudar a controlar o crescimento do peroxissomo”, disse Sapp. “Em nossos mutantes PEX11, essas vesículas não se formam ou são anormalmente pequenas e raras, então vemos esses peroxissomos gigantes, muito maiores que o normal”.
As descobertas não se limitam às plantas, mas também incluem outras espécies
Embora a pesquisa se concentrasse em plantas, Tharp questionou se o mesmo mecanismo existiria em outros organismos. Para testar essa ideia, ele introduziu uma versão de levedura da proteína, chamada Pex11, em células vegetais mutantes.
“Colocamos a levedura Pex11 em células vegetais mutantes para ver se ela poderia restaurar os peroxissomos ao normal”, disse Tharp. “De fato.”
Este resultado sugere que o Pex11 funciona nas leveduras de forma semelhante à sua função nas plantas, apesar da grande distância evolutiva entre elas. Por causa disso, a proteína também pode desempenhar funções semelhantes em outros tipos de células, incluindo células humanas.
“Descobrir que esta proteína desempenha o mesmo papel nas leveduras e nas células vegetais sugere que pode ser uma proteína altamente conservada”, disse Bartel. “Nossas descobertas em plantas, neste modelo relativamente fácil de estudar, podem, portanto, ser aplicáveis a células humanas e células usadas para bioengenharia”.